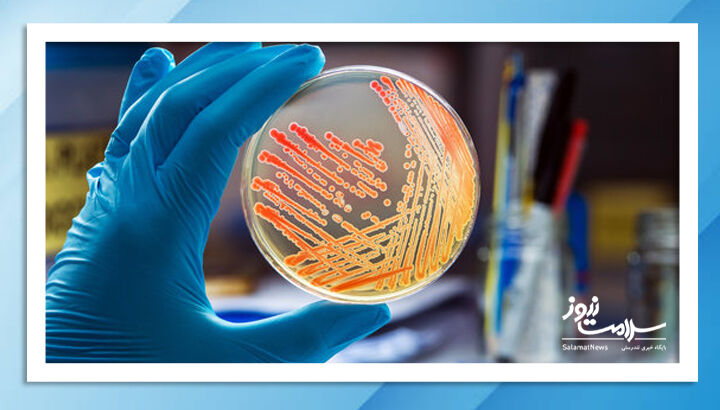

به گزارش سلامت نیوز به نقل از مایوکلینیک، عفونت شیگلا (شیگلوز) یک عفونت روده ای است که توسط خانواده ای از باکتری ها به نام شیگلا ایجاد می شود. علامت اصلی عفونت شیگلا اسهال است که اغلب خونی است.
شیگلا بسیار مسری است. افراد هنگام تماس با باکتری شیگلا و قورت دادن مقادیر کمی از مدفوع فردی که به شیگلا آلوده است، به آن مبتلا می شوند. به عنوان مثال، زمانی که کارکنان پس از تعویض پوشک یا کمک به کودکان نوپا در آموزش توالت، دست های خود را به اندازه کافی خوب نمی شویند، ممکن است به آن مبتلا شوند. باکتری شیگلا همچنین می تواند در غذای آلوده یا با نوشیدنی یا شنا در آب ناسالم نیز منتقل شود.
کودکان زیر 5 سال بیشتر از سایر گروه های سنی در معرض ابتلا به عفونت شیگلا هستند. یک مورد خفیف معمولاً در عرض یک هفته خود به خود برطرف می شود.
در صورت نیاز به درمان، پزشکان معمولا آنتی بیوتیک تجویز می کنند.
علائم عفونت شیگلا
علائم و نشانه های عفونت شیگلا معمولاً یک یا دو روز پس از تماس با شیگلا شروع می شود. اما ممکن است تا یک هفته طول بکشد تا توسعه یابد.
علائم و نشانه ها ممکن است شامل موارد زیر باشد:
- اسهال (اغلب حاوی خون یا مخاط)
- درد یا گرفتگی معده
- تب
- حالت تهوع یا استفراغ
علائم معمولاً حدود پنج تا هفت روز طول می کشد؛ با این حال در برخی موارد، علائم ممکن است بیشتر طول بکشد.
برخی از افراد پس از آلوده شدن به شیگلا هیچ علامتی ندارند. با این حال، مدفوع آنها ممکن است تا چند هفته همچنان مسری باشد.
چه زمانی باید به پزشک مراجعه کرد؟
اگر شما یا فرزندتان اسهال خونی یا اسهال شدیدی دارید که باعث کاهش وزن و کم آبی بدن شود، با پزشک خود تماس بگیرید یا به دنبال مراقبت فوری باشید. همچنین اگر شما یا فرزندتان دچار اسهال و تب 101 فارنهایت (38 درجه سانتیگراد) یا بالاتر هستید، با پزشک خود تماس بگیرید.
علل عفونت شیگلا
عفونت زمانی رخ می دهد که به طور تصادفی باکتری شیگلا را قورت دهید. این اتفاق ممکن است در موارد زیر اتفاق بیافتد:
- دهان خود را لمس می کنید: تماس مستقیم فرد به فرد شایع ترین راه انتشار این بیماری است. به عنوان مثال، اگر پس از تعویض پوشک کودک مبتلا به عفونت شیگلا، دست های خود را خوب نشویید، ممکن است خودتان نیز به این بیماری مبتلا شوید.
- غذای آلوده بخورید: افراد آلوده که غذا را کنترل می کنند می توانند باکتری را به افرادی که غذا می خورند گسترش دهند. اگر غذا در مزرعه ای حاوی فاضلاب رشد کند، می تواند به باکتری شیگلا نیز آلوده شود.
- آب آلوده قورت دهید: آب ممکن است به باکتری شیگلا آلوده باشد یا از فاضلاب یا از طریق شنا کردن فرد مبتلا به عفونت شیگلا در آن آلوده شوید.
عوامل خطر عفونت شیگلا
- سن: کودکان زیر 5 سال بیشتر در معرض ابتلا به عفونت شیگلا هستند. اما شیگلا می تواند افراد در هر سنی را مبتلا کند.
- زندگی در مسکن گروهی یا شرکت در فعالیت های گروهی: تماس نزدیک با افراد دیگر باعث انتشار باکتری از فردی به فرد دیگر می شود. شیوع شیگلا در مراکز مراقبت از کودکان، استخرها، خانه های سالمندان، زندان ها و پادگان های نظامی شایع تر است.
- زندگی یا مسافرت در مناطقی که فاقد سرویس بهداشتی هستند: افرادی که در کشورهای در حال توسعه زندگی می کنند یا به آنجا سفر می کنند بیشتر در معرض ابتلا به عفونت شیگلا هستند.
- همجنس گرایی: مردانی که با مردان رابطه جنسی دارند به دلیل تماس مستقیم یا غیرمستقیم دهانی مقعدی در حین فعالیت جنسی در معرض خطر ابتلا به عفونت شیگلا هستند.
عوارض عفونت شیگلا
عفونت شیگلا معمولاً بدون عارضه از بین می رود. اما ممکن است هفته ها یا ماه ها طول بکشد تا عادات روده شما به حالت عادی برگردد.
عوارض ممکن است شامل موارد زیر باشد:
- کم آبی بدن: اسهال مداوم می تواند باعث کم آبی بدن شود. علائم و نشانههای آن شامل سبکی سر، سرگیجه، کمبود اشک در کودکان، گودی چشم و خشکی پوشک است. کم آبی شدید می تواند منجر به شوک و مرگ شود.
- تشنج: برخی از کودکان مبتلا به عفونت شیگلا تشنج می کنند. تشنج در کودکانی که تب بالایی دارند بیشتر است، اما ممکن است در کودکانی که تب بالایی ندارند نیز رخ دهد. مشخص نیست که آیا این تشنج ناشی از تب است یا خود عفونت شیگلا. اگر کودک شما تشنج کرد، فورا با پزشک خود تماس بگیرید.
- افتادگی راستروده: در این شرایط، زور زدن در حین حرکات روده یا التهاب روده بزرگ ممکن است باعث شود غشای مخاطی یا پوشش راست روده از طریق مقعد به بیرون حرکت کند.
- سندرم همولیتیک اورمیک: این عارضه نادر شیگلا که بیشتر توسط یک نوع باکتری E. coli ایجاد می شود تا باکتری شیگلا، می تواند منجر به کاهش تعداد گلبول های قرمز خون (کم خونی همولیتیک)، تعداد کم پلاکت ها (ترومبوسیتوپنی) و نارسایی حاد کلیه شود.
- مگاکولون سمی: این عارضه نادر زمانی رخ می دهد که روده بزرگ فلج می شود و مانع از اجابت مزاج یا دفع گاز می شود. علائم و نشانه ها شامل درد و تورم معده، تب و ضعف است. اگر درمان مگاکولون سمی دریافت نکنید، ممکن است روده بزرگ شما پاره شود و باعث پریتونیت شود که یک عفونت تهدید کننده زندگی که نیاز به جراحی اورژانسی دارد.
- آرتریت واکنشی: آرتریت واکنشی در پاسخ به عفونت ایجاد می شود. علائم و نشانهها عبارتند از درد و التهاب مفاصل، معمولاً در مچ پا، زانو، پا و باسن. قرمزی، خارش و ترشح در یک یا هر دو چشم (کانژنکتیویت)؛ و ادرار دردناک (اورتریت).
- عفونت های جریان خون (باکتریمی): عفونت شیگلا می تواند به پوشش روده آسیب برساند. در موارد نادر، باکتری شیگلا می تواند از طریق پوشش آسیب دیده روده وارد جریان خون شده و باعث عفونت جریان خون شود.
جلوگیری از عفونت شیگلا
اگرچه محققان به کار برای ساخت واکسن شیگلا ادامه می دهند، اما هنوز چیزی در دسترس نیست. برای جلوگیری از گسترش شیگلا موارد زیر را رعایت کنید:
- دست ها را با آب و صابون حداقل به مدت 20 ثانیه مرتب بشویید.
- وقتی دستان کودکان خردسال را می شویید دستان خود را نیز خوب بشویید.
- پوشک های کثیف را به درستی دور بیندازید.
- پس از تعویض پوشک بدن کودک را به خوبی ضد عفونی کنید.
- اگر اسهال دارید برای دیگران غذا درست نکنید.
- کودکان مبتلا به اسهال را از مراقب کودک، گروه های بازی یا مدرسه دور نگه دارید.
- از بلعیدن آب از استخرها، دریاچه ها یا استخرهای تصفیه نشده خودداری کنید.
- از فعالیت جنسی با افرادی که اسهال دارند یا به تازگی از اسهال بهبود یافته اند خودداری کنید.
- تا بهبودی کامل به شنا نروید.

نظر شما